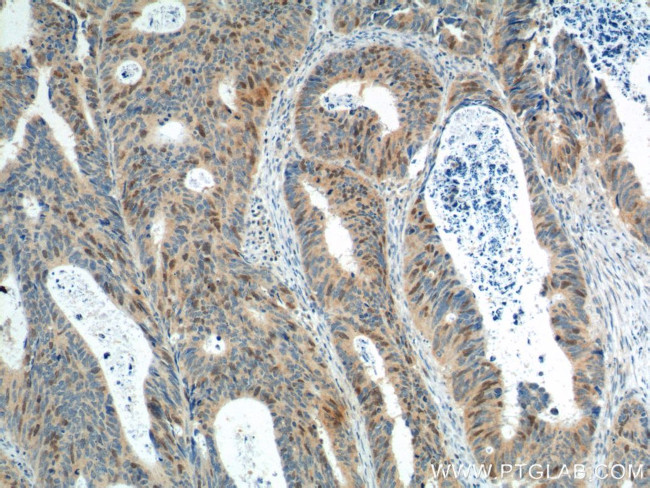
GMNN Antibody in Immunohistochemistry (Paraffin) (IHC (P))

Search
Proteintech
GMNN Monoclonal Antibody (2E3A2)
{{$productOrderCtrl.translations['antibody.pdp.commerceCard.promotion.promotions']}}
{{$productOrderCtrl.translations['antibody.pdp.commerceCard.promotion.viewpromo']}}
{{$productOrderCtrl.translations['antibody.pdp.commerceCard.promotion.promocode']}}: {{promo.promoCode}} {{promo.promoTitle}} {{promo.promoDescription}}. {{$productOrderCtrl.translations['antibody.pdp.commerceCard.promotion.learnmore']}}
产品信息
66566-1-IG
种属反应
宿主/亚型
分类
类型
克隆号
抗原
偶联物
形式
浓度
规格
纯化类型
保存液
内含物
保存条件
运输条件
产品详细信息
Immunogen sequence: MNPSMKQKQ EEIKENIKNS SVPRRTLKMI QPSASGSLVG RENELSAGLS KRKHRNDHLT STTSSPGVIV PESSENKNLG GVTQESFDLM IKENPSSQYW KEVAEKRRKA LYEALKENEK LHKEIEQKDN EIARLKKENK ELAEVAEHVQ YMAELIERLN GEPLDNFESL DNQEFDSEEE TVEDSLVEDS EIGTCAEGTV SSSTDAKPCI (1-209 aa encoded by BC005185)
靶标信息
GMNN inhibits DNA replication by preventing the incorporation of MCM complex into prereplication complex (pre-RC). It is degraded during the mitotic phase of the cell cycle. Its destruction at the metaphase-anaphase transition permits replication in the succeeding cell cycle.
仅用于科研。不用于诊断过程。未经明确授权不得转售。
篇参考文献 (0)
生物信息学
蛋白别名: Geminin; Geminin GMNN; OTTHUMP00000039393; RP3 369A17.3; similar to Xenopus laevis geminin; unnamed protein product
基因别名: Gem; GMNN; MGORS6
UniProt ID: (Human) O75496
Entrez Gene ID: (Human) 51053